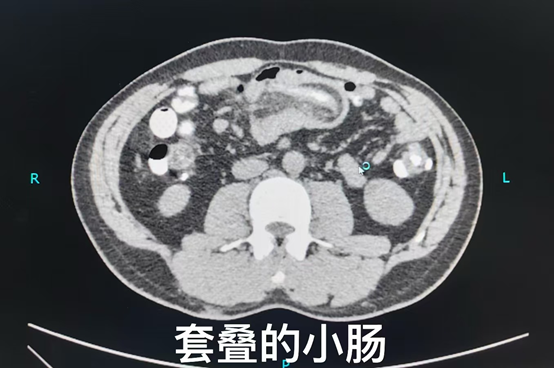

“这一个月来,腹痛真是把我折磨得够呛!多亏了北京中医医院的医生们才让我摆脱了这种折磨!”郑先生满脸笑容地说道。已回归正常生活的他眼神中充满了感激,曾经被腹痛困扰的阴霾一扫而空。
一个月前,郑先生的生活突然被一阵莫名的上腹间断性隐痛打破。腹痛间断性地发作,每次发作都让他痛苦不堪。而有一天腹痛毫无征兆地加重,刹那间席卷整个腹部,脐周更是疼痛的 “重灾区”。那阵发性绞痛,如同一颗颗炮弹在腹腔内爆炸,痛得郑先生满地打滚,他马上到首都医科大学附属北京中医医院急诊科就诊。“那种痛,就像有人在肚子里使劲绞我的肠子,每一秒都是煎熬。” 郑先生回忆起当时的情景,仍心有余悸。
普外/肿瘤外科副主任医师叶晋生接到通知后第一时间赶到急诊科,详细了解病史、进行查体,并完善盆腔CT提示肠系膜脂肪及血管进入肠腔上游部分,肠腔内可见气液平面,明确诊断郑先生出现了肠套叠。普外/肿瘤外科主任路夷平考虑到郑先生肠套叠已诱发肠梗阻表现,立即给予禁食水、下胃管胃肠减压、补液等对症治疗,并告知郑先生需要尽快手术。当得知可能需要切除一部分小肠时,郑先生的内心充满焦虑与恐慌。他害怕手术会带来各种并发症,担心自己以后无法正常工作,无法照顾家人。普外/肿瘤外科医疗团队为郑先生制定了详细的治疗方案并耐心地向郑先生解释病情和治疗方案,安抚他的恐惧情绪。“医生们都特别耐心,跟我讲了很多关于手术的事情,让我心里有了底,也没那么害怕了。”郑先生说道。
普外/肿瘤外科副主任叶晋生带领刘鹏医师、刘一博医师和王洁医师顺利完成了腹腔镜微创手术,解决病变的同时保证了肠道的通畅。术后,郑先生在医护人员的悉心照料下,恢复得十分顺利,很快就出院了。如今,他的腹痛症状消失,进食排便都恢复了正常,日常生活不再被疼痛困扰。
“肠套叠一般以腹痛、呕吐、血便为主要症状。对于病程较短、全身情况良好、无明显脱水及电解质紊乱、无腹膜炎等并发症的小儿肠套叠患者,可采用非手术治疗。对于成人肠套叠、小儿肠套叠病程较长、病情较重患者,通常需要手术治疗。”叶晋生表示,对于成年人,如发现肠道息肉、肿瘤等疾病,应及时就医治疗,避免病情发展引发肠套叠。此外,保持良好的生活习惯,如规律作息、适量运动、避免暴饮暴食等,有助于维持肠道正常功能,降低肠套叠的发病风险。尤其是对于有肠道疾病家族史或高危因素的人群,通过体检可以早期发现潜在的肠道问题,并采取相应的预防和治疗措施。
北京中医医院普外/肿瘤外科团队一直致力于为患者提供优质、高效的医疗服务,在面对各种复杂的外科疾病时,凭借专业的技术和温暖的关怀,为患者排忧解难,帮助他们重新拥抱健康生活。
北京中医医院肿瘤外科肠梗阻专病门诊介绍
肠梗阻是一种常见的外科疾病,指肠道的内容物无法正常转运和通过肠道。肠梗阻的症状与病因、部位以及病变程度有关,但最常见的症状包括阵发性腹痛、呕吐、无法排便和排气、腹胀等。此外,患者还可能出现口渴、脉搏细速、血压下降、四肢冷等全身性症状。
大多数情况下,经过及时有效的治疗,肠梗阻患者能够基本恢复正常,预后状况良好。然而,在严重的情况下,肠梗阻可能会危及生命。因此,一旦出现肠梗阻的症状,应及时就医,接受专业治疗。
特色优势
1、急性肠梗阻进行肠梗阻导管的置入,避免危及生命。
2、梗阻导管置入联合针灸和中药,能及时缓解症状,部分可治愈。
3、针对肿瘤、粘连等引起的严重肠梗阻,进行肠梗阻导管置入后,避免急诊开放手术,可择期行腹腔镜微创手术,最大程度降低手术创伤。
诊治范围
1、结直肠肿瘤、小肠肿瘤等引起肿瘤性肠梗阻。
2、嵌顿性腹股沟疝、嵌顿性切口疝、嵌顿性腹内疝、肠扭转等引起急性肠梗阻。
3、腹部术后等引起粘连性肠梗阻。
4、肿瘤放疗后引起的放射性肠梗阻。
5、其它各种原因引起的肠梗阻。
出诊专家
路夷平,主任医师,外科诊疗中心学术带头人
出诊时间:周二上午
叶晋生,副主任医师,外科诊疗中心肿瘤外科副主任,外科教研室主任
出诊时间:周二下午、周四上午
肠梗阻专病门诊时间
周一至周日全天


